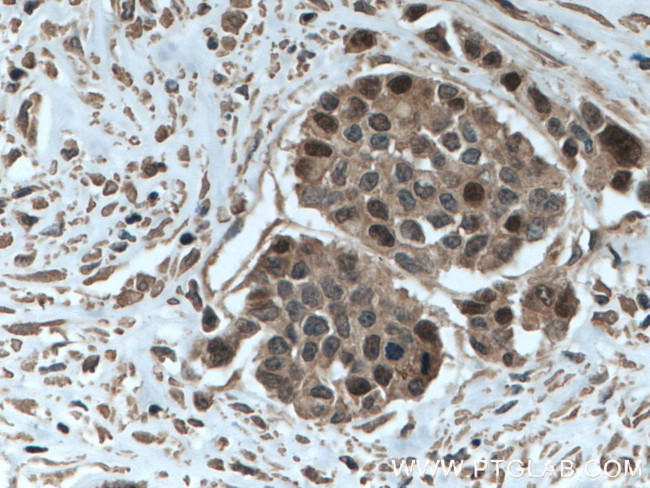
TYMS Antibody in Immunohistochemistry (Paraffin) (IHC (P))

Search
Proteintech
TYMS Monoclonal Antibody (1F5B7)
{{$productOrderCtrl.translations['antibody.pdp.commerceCard.promotion.promotions']}}
{{$productOrderCtrl.translations['antibody.pdp.commerceCard.promotion.viewpromo']}}
{{$productOrderCtrl.translations['antibody.pdp.commerceCard.promotion.promocode']}}: {{promo.promoCode}} {{promo.promoTitle}} {{promo.promoDescription}}. {{$productOrderCtrl.translations['antibody.pdp.commerceCard.promotion.learnmore']}}
产品信息
66725-1-IG
种属反应
宿主/亚型
分类
类型
克隆号
抗原
偶联物
形式
浓度
规格
纯化类型
保存液
内含物
保存条件
运输条件
产品详细信息
Immunogen sequence: MPVAGSELP RRPLPPAAQE RDAEPRPPHG ELQYLGQIQH ILRCGVRKDD RTGTGTLSVF GMQARYSLRD EFPLLTTKRV FWKGVLEELL WFIKGSTNAK ELSSKGVKIW DANGSRDFLD SLGFSTREEG DLGPVYGFQW RHFGAEYRDM ESDYSGQGVD QLQRVIDTIK TNPDDRRIIM CAWNPRDLPL MALPPCHALC QFYVVNSELS CQLYQRSGDM GLGVPFNIAS YALLTYMIAH ITGLKPGDFI HTLGDAHIYL NHIEPLKIQL QREPRPFPKL RILRKVEKID DFKAEDFQIE GYNPHPTIKM EMAV (1-313 aa encoded by BC002567)
靶标信息
Thymidylate Synthase (TS) converts deoxyuridine monophosphate (dUMP) to deoxythymidine monophosphate (dTMP), which is essential for DNA biosynthesis. TS is a critical target for the fluoropyrimidines, an important group of antineoplastic drugs that are widely used in the treatment of solid tumors. Both 5-FU and fluorodeoxyuridine are converted in tumor cells to FdUMP which inactivates TS by formation of a ternary covalent complex in the presence of the folate cofactor 5,10-methylenetetrahydrofolate. Expression of TS protein is associated with response to 5-fluorouracil (5-FU) in human colorectal, gastric, head and neck, and breast carcinomas.
仅用于科研。不用于诊断过程。未经明确授权不得转售。
生物信息学
蛋白别名: MGC88736; Thymidylate synthase; TS; TSase; tysy; unnamed protein product
基因别名: DKCD; HST422; OK/SW-cl.29; TMS; TS; TYMS
UniProt ID: (Human) P04818
Entrez Gene ID: (Human) 7298